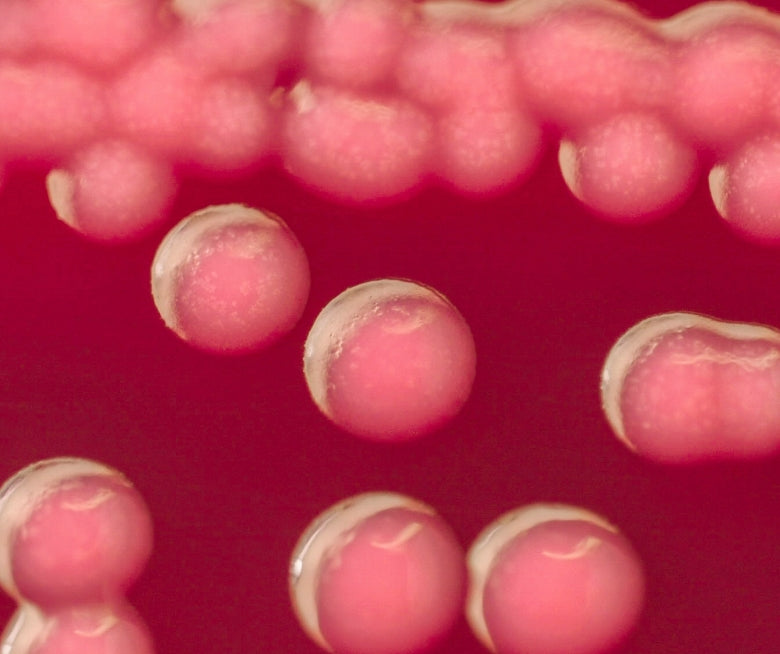

Women's Microflora Probiotic




Women's Microflora Probiotic
A premium, targeted probiotic formula containing 6 strains of beneficial bacteria. It includes Lactobacillus crispatus, which is commonly found in a healthy vaginal microbiome.
Key Benefits
- Support everyday health and wellbeing
- Maintain vaginal health
- Support a healthy vaginal microbiome
L. = Lactobacillus
Mostly found in such as the digestive system, urinary system, and genital system
CFU = Colony Forming Units
Unit of measurement used for probiotics and other bacteria.
EACH VEGETARIAN CAPSULE CONTAINS 6.3 BILLION CFU
| PROBIOTIC STRAIN | CFU |
| L. crispatus LBV88 | 2.0 Billion |
| L. plantarum I1001 | 1.0 Billion |
| L. reuteri (RC-14) | 1.0 Billion |
| L. rhamnosus (GR-1) | 1.0 Billion |
| L. rhamnosus LBV96 | 1.0 Billion |
| L. gasseri LBV 150 N | 300 Million |
Adults take 1 vegetarian capsule daily with water, or as directed by your health professional.
Store below 30°C in a dry place. Use within 3 months of opening. No refrigeration required.
Size "2" clear hard vege-capsule containing light to red pink mottled free-flowing powder.
The Life-Space difference
 6 strains of beneficial bacteria
6 strains of beneficial bacteria
 Live bacteria guarantee
Live bacteria guarantee
 No refrigeration required
No refrigeration required
 Naturally sourced probiotics
Naturally sourced probiotics
 Vegetarian friendly
Vegetarian friendly
 No added dairy, gluten or egg
No added dairy, gluten or egg
 No added preservatives or artificial colours
No added preservatives or artificial colours
 Formulated, blended and packaged in Australia
Formulated, blended and packaged in Australia
Key Ingredients & Their Benefits

Supports healthy vaginal microflora and maintains vaginal health.
One of the most common bacterial species found in a healthy vaginal microbiome.

FAQs
How can probiotics help vaginal health?
Naturally occurring Lactobacilli bacteria, including L.crispatus and L. gasseri, play an important role in maintaining the health of your vagina. Lactobacilli are known for their ability to produce a substance known as lactic acid, an important substance which helps support a healthy vaginal microbiome. Whilst the thought of an acidic vaginal environment conjures up images of intense discomfort, it is generally considered a good thing, playing a protective role by keeping less vagina-friendly species of bacteria at bay. An abundance of Lactobacilli bacteria is considered a sign of a healthy vaginal microbiome in the majority of women.
Can I take this while I am pregnant / breastfeeding?
Yes, this product can be taken during pregnancy or breastfeeding. If you are breastfeeding, we have the Breastfeeding Probiotic, which is specifically formulated for this life-stage.
I usually take Broad Spectrum Probiotic but would also like to take Women's Microflora Probiotic. Can these be taken together?
Yes, Women’s Microflora Probiotic and Broad Spectrum Probiotic can be taken at the same time. Please ensure that you follow the label directions.
Why are there light pink specks in the product?
This product contains Lactobacillus crispatus LBV 88, which can present as coloured specks ranging from beige to light orange or light pink. This variation in colour is normal and expected and does not represent a quality issue.
What is the difference between Women's Microflora Probiotic and Urogen Probiotic for Women?
Women’s Microflora is a probiotic-only product that specifically supports the vaginal microbiome. Urogen Probiotic for Women contains cranberry extract in addition to probiotics, and helps support urinary tract health.
Can I use Women’s Microflora Probiotic as a vaginal pessary?
Women’s Microflora has been formulated to be taken orally and is not designed for use as a vaginal pessary.
Can this product be used over long period of time?
Yes, this product is suitable for long-term use.
Can Women’s Microflora and Urogen Probiotic for Women be taken together?
Yes, Women’s Microflora and Urogen Probiotic for Women can be taken concomitantly, however combined dosing will lead to high doses of RC-14 and GR-1, which may not provide additional benefit. Ensure you follow the label dosage instructions, taking one of each per day. For further assistance please contact your healthcare professional.
Can I take this product while taking antibiotics or antifungals?
Probiotics should be taken at least 2-3 hours before or after antibiotic and/or antifungal medications.
Can I take this product for candida/yeast infection?
This product has been formulated to support a healthy vaginal microbiome. It has not been formulated to treat candida/yeast infections. Please consult your healthcare professional for tailored advice.
Can I use while pregnant or breastfeeding?
Yes, this product can be used safely during pregnancy and breastfeeding . Probiotics have not been reported to pose any safety risk for pregnant women.
Cranberry - From the limited information available, maternal use of cranberry has not been associated with an increased risk of congenital malformations or adverse pregnancy outcomes. Cranberry is considered safe to use when consumed in amounts commonly found in foods or when used as adjunctive therapy for urinary tract infection. However, the most suitable product during this stage of life is the Probiotic+ Pregnancy & Breastfeeding product. Therefore use in pregnancy should be under the supervision of a healthcare practitioner.
- YiI recommend this productRated 5 out of 5 stars2 years agoPregnancy safe
May I know is this pregnancy safe?
Was this helpful?LPLife-Space Probiotics2 years agoHi Yi,
This product can be taken during pregnancy. However, we would recommend taking the Probiotic + Pregnancy & Breastfeeding instead as it is specifically formulated to provide support for this life stage. - Minh N.Verified ReviewerI recommend this productRated 5 out of 5 stars2 years agoWhat’s the difference between Microflora probiotics and Menopause probiotics?
Hi, can you let me know What’s the difference between Microflora probiotics and Menopause probiotics? I just finished 1 bottle of Life Space Menopause probiotics but im a bit confused about these two? Im 48 years old. thank you 😊
Was this helpful?LPLife-Space Probiotics2 years agoHi Minh,
Thank-you for reaching out to us. The Women's Microflora Probiotic supports and helps maintain a healthy vaginal microbiome whilst the Menopause Support probiotic also assists on reducing hot flushes in menopausal women while supporting a healthy vaginal microbiome.
Hope this has provided you with clarification. - LaicaVerified ReviewerI recommend this productRated 5 out of 5 stars5 months agoNice Product! Just have one question tho
Can I drink this together with the Life Space Acne Relief??
Was this helpful?LPLife-Space Probiotics12 seconds agoHi Laica,
Yes, these products can be taken simultaneously as they have different actions.
Kind Regards,
The Life-Space Team - MonI recommend this productRated 5 out of 5 stars8 months agoWork amazingly
These were my last resort after trying multiple things - Canestan, Boric Acid, switching to bamboo underwear and Candida cleanse for thrush. These have been amazing to keep everything in order down there and haven't had any symptoms since taking them everyday.
Was this helpful?LPLife-Space Probiotics8 months agoHey Mon, thank you so much for the review. We are pleased to hear that our products are working so well for you
- ElleVerified ReviewerI recommend this productRated 5 out of 5 stars11 months agoFabulous product
I went through menopause, was diagnosed with diabetes and have to take a diabetic medication that causes thrush. Then I had surgery and had to take a rather nasty antibiotic.
All of which resulted in my digestive and vaginal flora being turned upside down.
I began taking the double strength probiotic then after a couple of months moved onto the women’s probiotic.
Both have been highly effective in balancing the flora.
This has completely changed my life.
Thank you so much for making a highly effective product.
Was this helpful?LPLife-Space Probiotics9 months agoHi Elle,
Thanks for your review - it's great to hear that these products have been so effective for you
You may also like
Broad Spectrum Probiotic Advanced
Broad Spectrum Probiotic Advanced
Pickup currently not available
Acne Relief + Skin Rebalance Probiotic
Acne Relief + Skin Rebalance Probiotic
Pickup currently not available
Double Strength Probiotic
(1)
Double Strength Probiotic
Pickup currently not available
Triple Strength Probiotic
(2)
Triple Strength Probiotic
Pickup currently not available
Triple Strength Probiotic Powder
Triple Strength Probiotic Powder
Pickup currently not available
Probiotic for 60+ Years
(6)
Probiotic for 60+ Years
Pickup currently not available
Probiotic Powder for Baby
(2)
Probiotic Powder for Baby
Pickup currently not available
Probiotic Powder for Children
Probiotic Powder for Children
Pickup currently not available
Women's Microflora Probiotic
(15)
Women's Microflora Probiotic
Pickup currently not available
Urogen™ Probiotic for Women
(5)
Urogen™ Probiotic for Women
Pickup currently not available
Immune Support Probiotic
(1)
Immune Support Probiotic
Pickup currently not available
Children Immune Support Probiotic
Children Immune Support Probiotic
Pickup currently not available
Learn More About Your Health


























